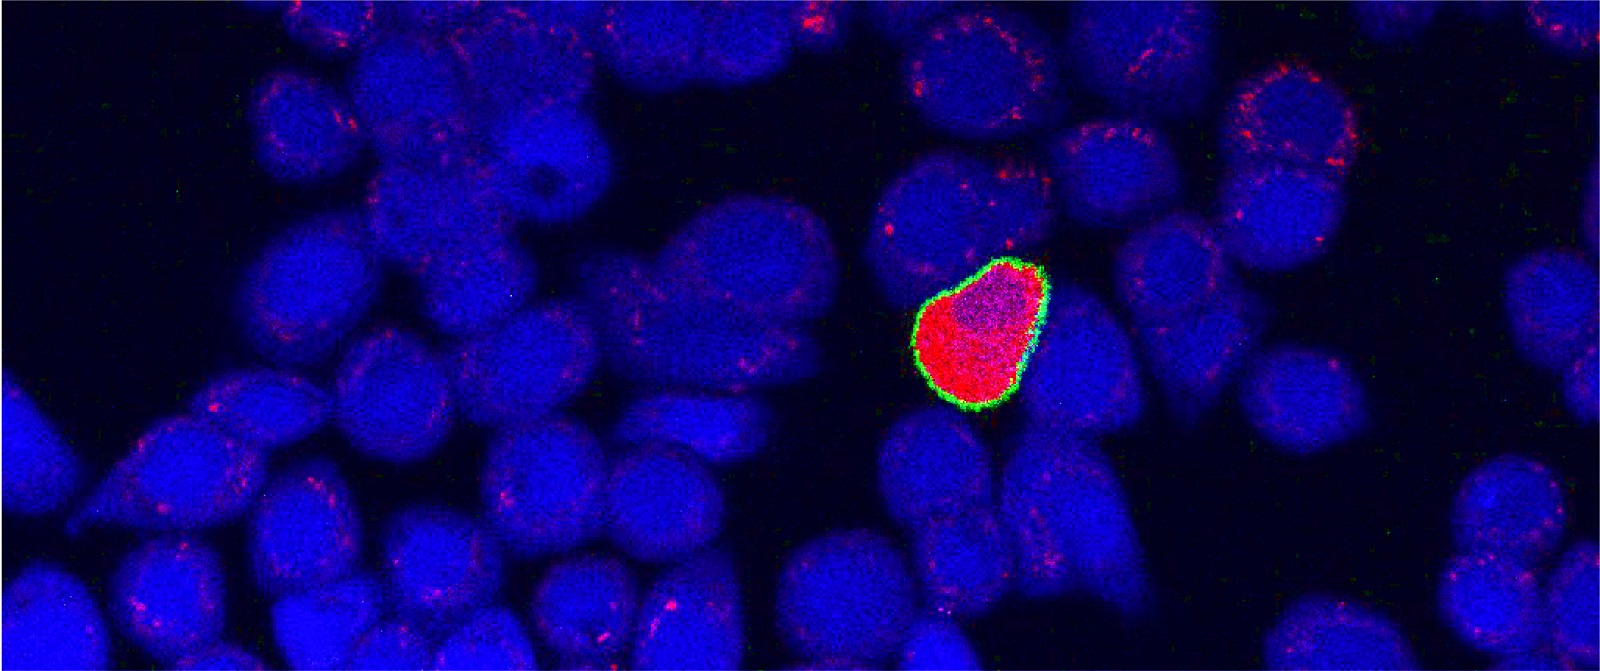

Recherche
Le thème de recherche fondamentale du PRN est de s’inspirer de la nature pour la conception de nouveaux matériaux artificiels qui peuvent changer leurs propriétés « sur commande », autrement dit en réponse à une stimulation externe. Ces matériaux dits parfois « intelligents » sont d’un intérêt fondamental pour les scientifiques et potentiellement utiles dans de nombreuses applications qui peuvent aller du contrôle de systèmes de climatisation aux systèmes de distribution de médicaments.
Au cours de la phase 1 (2014-2018) et de la phase 2 (2018-2022), les scientifiques du PRN ont ouvert de nouveaux domaines de recherche et de nouvelles opportunités de recherche dans des domaines existants, notamment le recyclage des polymères inspiré par la nature, l'émulsification à haut débit, des nouveaux matériaux sensibles au stress mécanique et les organoïdes « on-a-chip » permettant la création de tissus biologiques.
Avec le soutien du FNS et de l'Université de Fribourg, le centre est entré dans sa troisième et dernière phase de financement (2022-2026) avec pour objectifs de continuer à mener des recherches de pointe, d'augmenter le nombre de collaborations entre les différentes disciplines représentées dans le centre, de se concentrer sur la recherche translationnelle dans le domaine des matériaux bio-inspirés et de consolider la structure de centre qui portera l'héritage du PRN au-delà de la fin de la phase 3.
Au cours de la phase 3, le programme de recherche du PRN est organisé en trois modules thématiques axés sur les matériaux sensibles au stress mécanique, les matériaux photoniques et les bio-interfaces réactives, ainsi qu'un module comprenant quatre projets axés sur la recherche translationnelle.
-
Module 1. Matériaux mécaniquement réactifs

Les matériaux sensibles au stress mécanique sont largement exploités par les organismes vivants dans la nature pour fournir une variété de fonctions biologiques, telles que la protection contre les prédateurs et les changements de forme, ainsi que la détection des stimuli externes et l'activation des réponses pertinentes. Les fonctions émergent souvent de processus biochimiques entraînés mécaniquement qui peuvent se dérouler à différentes échelles de longueur dans le matériel biologique. Quelques exemples qui se produisent à des échelles progressivement plus grosses sont les changements conformationnels induits par le stress des protéines des membranes cellulaires, la variation mécanique de la perméabilité ionique des organites cellulaires, la rupture par cisaillement des micro-conteneurs et l'action orchestrée de multiples cellules dans les tissus en régénération. Ces phénomènes mécaniques contrôlent l'adhérence et la perméabilité des membranes cellulaires, permettent la libération d'espèces réactives dans l'environnement et déclenchent les mécanismes complexes qui permettent l'auto-guérison, la régénération et le remodelage des tissus.
Inspiré par ce riche répertoire de matériaux biologiques, et s'appuyant sur les résultats du module dans les phases 1 et 2 (2014-2022), le module 1 continuera à développer des matériaux bio-inspirés qui imitent les tissus vivants et leur réponse aux stimuli externes. Dans la phase 3 (2022-2026), l'équipe est interdisciplinaire et comprend d'anciens membres des modules 1 et 3 ainsi qu'un nouveau groupe de recherche de l'Empa, et combine des compétences en chimie des polymères, en biophysique et en biologie computationnelle.
-
Module 2: Matériaux photoniques

Les couleurs brillantes des plantes, des insectes, des oiseaux et des mammifères sont parmi les exemples les plus intéressants et les plus attrayants de la façon dont la nature crée des matériaux complexes et les utilise pour des fonctions spécifiques telles que la signalisation ou le camouflage. La diversité des organismes biologiques et de leurs environnements très différents a conduit dans le cours de millions d’années à une variété illimitée de processus d'assemblage au niveau moléculaire donnant des matériaux aux architectures très complexes. Dans la vie quotidienne, les revêtements et pigments colorés jouent un rôle important dans une variété d'applications et de produits de consommation tels que les peintures, les aliments, les écrans, les emballages et les filtres optiques. Les objectifs des applications industrielles sont souvent à l'image des défis auxquels la nature est confrontée : haute pureté de la couleur, densité optique, stabilité de blanchiment et longue durée de vie.
Dans le module 2, nous nous efforçons de tirer parti de l'inspiration donnée par la nature pour mieux comprendre et exploiter l'assemblage biologique de matériaux optiques. Une pléthore d'organismes utilisent des morphologies photoniques 2D et 3D de l'ordre de la centaine de nanomètres pour générer de la couleur par interférence, ce qui est difficile ou impossible à imiter par des méthodologies dites « top-down ». S'appuyant sur les études des structures photoniques dans la nature des phases 1 et 2, tous les projets de la phase 3 se concentrent sur l'assemblage (méthodologie « bottom-up ») de matériaux photoniques inspirés par ces projets antérieurs. La recherche de ce module rassemble des compétences complémentaires en chimie, colloïdes, physique, scattering, physique computationnelle et nanoparticules avec une équipe interdisciplinaire formée par d'anciens membres des modules 1, 2 et 3.
-
Module 3. Bio-interfaces réactives
Le sort et la fonction des matériaux biologiques synthétiques sont souvent déterminés par ses interactions avec les tissus vivants, notamment au niveau des interfaces. Au cours des phases 1 et 2 (2014-2022), le module 3 s'est concentré sur le développement de matériaux pour diriger la croissance cellulaire et la différenciation des tissus, induire ou inhiber des réponses cellulaires spécifiques, détecter des biomarqueurs dans des environnements complexes et dilués et inhiber les infections virales, entre autres. Dans la phase 3 (2022-2026), le module 3 devient un programme de recherche multidisciplinaire impliquant des groupes de recherche de tous les anciens modules thématiques de la phase 2. Sous le thème commun "bio-interfaces réactives", les projets visent des objectifs divers, notamment le développement des supports permettant la croissance guidée des tissus, l'impression 3D d'organoïdes de taille centimétrique à température ambiante, l’étude des mécanismes moléculaires favorisant ou entravant la stabilité des dispersions protéiques, l'introduction de nouvelles surfaces antivirales et antimicrobiennes, la conception de nanocapteurs à base d'ADN-Origami pour la détection du cancer et le développement de batteries à base de matériaux 2D.
-
Projets de transfert de technologie

Conformément à sa stratégie visant à mettre l'accent sur la recherche translationnelle au cours de la phase 3, le PRN a lancé un nouveau module comprenant quatre projets de recherche qui viseront le développement de matériaux bio-inspirés avec potentiel d’application. Ces projets s'appuient sur la recherche fondamentale menée au cours des deux premières phases du PRN et visent à développer des technologies tangibles d'ici la fin de la phase 3 en partenariat avec des partenaires industriels.
Les participants à ces projets suivront des formations sur les thèmes de l'innovation et du transfert de la technologie organisés par le PRN et par Innosuisse. Ils auront également la possibilité d'effectuer des stages en entreprise et seront suivis de façon personnalisée par le responsable TT du PRN.
